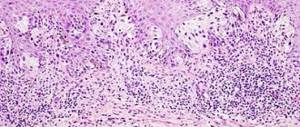

- Варианты операции
- Показания к операции
- Как подготовится
- Как проходит операция
- Восстановительный период
- Осложнения
- Цена пересадки
- Клиники
Кератопластика — это широкий термин, который включает все офтальмологические хирургические операции, выполняемые на роговице.
Здоровая роговица должна быть чистой, гладкой и прозрачной для хорошего зрения. Если на ней есть шрамы, опухоли или поврежденные участки, свет не может фокусироваться должным образом. В результате ваше зрение размыто или вы видите блики.
Роговица во многих случаях не может быть излечена или восстановлена естественным путем. В этом случае зрение может восстановить кератопластика — операция, когда больная роговица заменяется здоровой от человека-донора или искусственным имплантом. https://ultrastom.shop/magazin/folder/sovmestimo-s-neobiotech
Показания к трансплантации роговицы
Замена роговицы глаза необходима, если консервативные и другие методики лечения не оказывают нужного действия. Определить, когда следует проводить операцию, может только специалист, опираясь на множество фактов, поскольку процесс восстановления глаза — процедура достаточно длительная. В большей части ситуаций такая процедура – единственный способ борьбы с дефектами. Чаще всего трансплантация ткани нужна:
- при врожденных и приобретенных истончениях роговицы;
- при буллезной кератопатии;
- при образовании рубцов после операции и ожогов;
- при спайках, появившихся после инфекции или вирусного заболевания;
- после ожога химическими средствами с осложнениями;
- при наличии глаз неправильной формы.
Противопоказания
Как и большинство других операций, кератопластика имеет противопоказания, запрещающие ее проведение. Проблемы с сердечно сосудистой системой и нарушения в легких считаются относительными запретами, при которых врач взвешивает возможные риски и ожидаемый эффект. Поводом для отсрочки даты пересадки может быть наличие локальных очагов воспаления.
В таком случае проводится лечение заболевания и только после можно думать о кератопластике.
Категорическим запретом для проведения пересадки роговицы является:
- воспалительные процессы на глазах;
- закупорка слезных каналов;
- сильное повышение давления внутри глаз;
- гемофилия, развитие которой началось на фоне сахарного диабета;
- наличие кровеносного бельма.
Крайне редко трансплантация роговицы проводится в период вынашивания ребенка и при кормлении грудью. Как правило, при необходимости такой операции ее откладывают. Поскольку определенный период после хирургического вмешательства следует принимать медикаменты, влияние на детей которых не изучено.
Виды кератопластики
Полная пересадка
Она может потребоваться, если повреждены и наружный, и внутренний слои роговицы. Это называется проникающей кератопластикой (ПK) или трансплантацией полной толщины. Больная или поврежденная роговица удаляется. Затем прозрачная донорская роговица пришивается на ее место. Несмотря на наибольшую из всех вариантов травматичность — это самый простой вариант кератопластики.
ПК имеет более длительный период восстановления, чем другие виды трансплантации роговицы. Восстановление полного зрения после ПК может занять до одного года или дольше.
С ПK существует более высокий риск отторжения трансплантата, чем с другими типами пересадки роговицы.
Частичная пересадка роговичного трансплантата
Иногда повреждены только передний и средний слои. В этом случае удаляются только эти слои. Эндотелиальный тонкий задний слой, остается на месте. Этот трансплантат называется глубокой передней пластинчатой кератопластикой (DALK) или трансплантацией роговицы частичной толщины. DALK обычно назначается для лечения кератоконуса или выпячивания роговицы.
Время заживления после DALK короче, чем после полной трансплантации роговицы. Также меньше и риск отторжения новой роговицы. Эта операция — более сложная, и в СНГ выполняется лишь ограниченным количеством клиник.
В Бельгии проводятся все современные операции по трансплантации роговицы, в том числе DALK. В некоторых клиниках вмешательство выполняется с помощью фемтосекундного лазера, что делает её более безопасной.
Глубокая передняя ламеллярная кератопластика (DALK) предполагает иссечение роговицы до уровня десцеметовой мембраны. На глазу реципиента формируют несквозной диск роговицы. Выкроенный сквозной донорский диск без эндотелия укладывается на освобожденную от поверхностных слоев стромы десцеметовую мембрану реципиента и фиксируется швами. Главным преимуществом метода считается минимальный риск отторжения трансплантата.
После DALK трансплантат становится прозрачным уже на 3-5 сутки после операции. Операция обеспечивает лучшие функциональные результаты: после приживления трансплантата достигается острота зрения 0,7-0,9, а некоторые пациенты получают стопроцентное зрение.
Операции по трансплантации роговицы проводятся в клинике Сен-Жан командой врачей под руководством доктора Жерома Вригем (Dr. Jérôme Vryghem). Этот специалист выполняет больше 2 тысяч офтальмологических вмешательств каждый год. С 2007 года он одним из первых в Бельгии начал использовать фемтосекундный лазер. Эта технология позволяет выполнять более точные разрезы ткани роговицы в произвольном варианте. Фемтосекундный лазер дает возможность индивидуально подходить к выбору способа операции.
Эндотелиальная кератопластика
При некоторых заболеваниях глаз поврежден самый внутренний слой роговицы, называемый «эндотелий». Это вызывает отек роговицы, влияющий на ваше зрение. Эндотелиальная кератопластика — это операция по замене этого слоя роговицы на здоровую донорскую ткань.
Поврежденный слой роговицы удаляется через небольшой разрез. Затем новая ткань ставится на место. Для закрытия разреза требуется всего несколько швов, если они есть. Большая часть роговицы остается нетронутой. Это снижает риск отторжения новых клеток роговицы после операции.
Существует два вида эндотелиальной кератопластики.
- DSEK (или DSAEK) — эндоскопическая кератопластика десцеметовой мембраны (автоматизированная). При операции DSEK / DSAEK донорскую ткань легче пересаживать и позиционировать, потому что она толще донорской ткани при операции DMEK. Поэтому такая операция более распространена.
- DMEK — Мембранная эндотелиальная десцеметовой мембраны. В хирургии DMEK донорская ткань тонкая и может быть более трудной для пересадки. Но выздоровление идет быстрее и отдаленные результаты операции лучше, потому что ткань трансплантата тоньше. Но эту операцию выполняют за рубежом только в офтальмологических центрах с самым высоким уровнем технического оснащения и подготовки хирургов. В Бельгии этот метод внедрен с 2012 года.
Искусственный имплант роговицы
При такой операции искусственный гибкий кератопротез имплантируется в роговичный карман с помощью минимально инвазивной процедуры.
Существует большое несоответствие между доступностью ткани роговицы для трансплантации и количеством пациентов, нуждающихся в пересадке роговицы. Искусственные импланты способны решить эту проблему. Но только в последние несколько лет они смогли обеспечивать уровень восстановления зрения, сравнимый с донорской роговицей.
Сейчас у больных с высоким риском отторжения с донором-человеком, кератопротез может обеспечить хорошие визуальные результаты с хорошим соотношением риска и пользы.
Бионический имплант роговицы
Это инновационный метод, который только входит в практику ведущих офтальмологических клиник в Европе. Протез роговицы создается методом 3D-печати из децеллюляризованной стромы роговицы и стволовых клеток.
Эта роговица полностью биосовместима, а технология трехмерной клеточной печати позволяет воспроизводить микросреду роговицы. В результате прозрачность импланта аналогична человеческой роговице.
Подготовка к кератопластике
Когда принято решение пересаживать роговицу, пациент проходит полное обследование. В случае выявлений каких-либо проблем со здоровьем его направляют на консультирование к специалистам узкой направленности, которые назначают лечение. Таким образом, исключается развитие проблем с функционированием жизненно важных органов.
В случае наличия глазных заболеваний, которые могут негативно отобразиться на трансплантации, их также нужно вылечить. К таким болезням относят:
- патологии век;
- воспалительный процесс конъюнктивы и склеры;
- воспаление сосудов глаза;
- наличие некомпенсированной глаукомы.
Пройти полный курс лечения глазных заболеваний необходимо, поскольку имеющееся воспаление может перейти на пересаженную роговицу. Непосредственно перед оперированием делается посев из конъюнктивальной оболочки для выявления возбудителя и чувственности к антибактериальным средствам. Изначально применяется антибиотик широкого спектра действия, и в дальнейшем терапия корректируется, исходя из результатов посева.
Как проходит пересадка
Трансплантировать роговицу можно только в стационаре. На операцию выделяют 1 день без последующей госпитализации. Специалист проводит предоперационную диагностику, после которой точно известны размеры оболочки, какую нужно удалить. Также дополнительно готовится донорский материал, который полностью соответствует размеру удаляемой оболочки. Операция осуществляется под микроскопом.
Веко глаза необходимо зафиксировать с использованием векорасширителя. Используя лазер, специалист удаляет часть роговичной ткани, на место которой накладывается донорская роговица. Пересаженный материал фиксируется с помощью швов по всему контуру.
При удалении передней части роговицы операция считается более легкой. При полной замене роговицы увеличивается риск отторжения ткани. Швы снимаются специалистом не ранее чем через 4 месяца. Процесс заживления может длиться и больше года в зависимости от глубины операции.
Глаз после операции
На протяжении нескольких дней после кератопластики пациент находится под строгим наблюдением врачей. На протяжении этого времени важно принимать гормонотерапию, антибиотики и средства для ускоренного заживления ран. Все это время прооперированный глаз находится под стерильными повязками.
После выписки пациент продолжает восстановление самостоятельно, соблюдая рекомендации специалистов по поводу закапываний полости конъюнктивы. Для этого используют:
- гормональный раствор, чтобы снизить вероятность отторжения пересаженного материала;
- антибиотики;
- препараты, заменяющие натуральную слезу;
- Декспантенол гель.
На восстановление нормального функционирования роговицы, как правило, уходит не меньше года. Но даже в случае отсутствия осложнений восстановить зрение удается не сразу. Неопределенный период времени пациенты могут видеть искаженные картинки, страдать от светобоязни. В среднем на восстановление зрения уходит несколько месяцев, в отдельных случаях этот период может затягиваться.
Все это время специалист помогает подобрать оптику на время, которая помогает нормально воспринимать окружающий мир. Также существуют некоторые рекомендации, соблюдение которых обязательно на протяжении всего периода:
- следует исключать сильные физические нагрузки;
- ограничить влияние яркого света, защищая глаза солнечными очками;
- стараться не болеть простудными заболеваниями;
- отказаться от посещения мест с высокими температурами;
- не касаться глаз, чтобы потереть, исключить надавливания;
- спать на противоположном боку от пересаженной роговицы;
- не допускать попадание пыли и других загрязнений в глаза;
- использовать все назначенные препараты.
Бионический глаз
Как уже было сказано, пересадка сетчатки на данном этапе развития медицины невозможно из-за особенных функций этой оболочки глаза и ее тесной связи с головным мозгом. Однако, исследования в этой области ведутся активно, так как успех такой операции позволит вернуть зрения многим пациентам с тяжелыми заболевания и даже тем, кто от рождения слеп.
Отслойка сетчатки глаза
Прорывом в этой области офтальмологии можно считать событие, произошедшее в 2015 году в Англии. Специалистами был вживлен бионический глаз 80-летнему пациенту Рою Флинну, который проживал в графстве Большой Манчестер г. Оденшоу. Мужчина уже многие годы мучился от возрастной макулодистрофии (поражение сетчатки), которая является одной из самых частых причин слепоты людей старше 55 лет.
Уникальную экспериментальную процедуру выполнили 18.06.2015 года специалисты из Королевского офтальмологического госпиталя в Манчестере, который является одним из ведущих офтальмологических центров в мире.
Бионический протез Argus II был разработан американской компанией Second Sight. Он состоит из 2 основных частей. Первая представляет собой имплантат сетчатой оболочки, который вживляют пациенту. Вторая – наружная система, которая содержит мини-камеру с процессором, вмонтированную в обычные, на первый взгляд, очки. Камера фиксирует происходящее вокруг в режиме реального времени, затем полученную информацию обрабатывает процессор и передает в имплантат. Последний стимулирует те здоровые клетки сетчатки, которые остались у пациента. В результате информация направляется в зрительный нерв и головной мозг начинает вновь различать предметы, их формы и свет.
Рой Флинн – пациент, которому удалось вернуть зрение после пересадки бионического глаза
Интересно! Бионический глаз был вживлен еще 130 пациентам, но случай Роя оказался особо успешным. Уже по прошествии 1 недели после экспериментальной процедуры мужчина смог не только вновь видеть все вокруг, но и даже читать текст на экране монитора, причем даже с закрытыми глазами.
Стоимость бионического протеза Argus II составляет 150 тысяч евро. Но исследователи намерены продолжать вживлять такие имплантаты бесплатно пациентам, как в случае Роя Флинна, так как подобный результат можно назвать событием, которое дает надежду миллионам слепых вновь увидеть окружающий мир и близких людей.
Возможные осложнения
О том, что после операции могут возникать различные осложнения, пациентов предупреждают до начала пересадки. Также негативные проявления могут возникать и в процессе кератопластики.
Наиболее небезопасным осложнением считается отторжение организмом донорской роговицы. В таком случае возникает необходимость дополнительной операции. То есть первая пересадка считается бесполезной, а любое промедление с повторной операцией может быть причиной сильного ухудшения качества зрения.
Следует понимать, что отвергнуть пересаженный материал организм может независимо от периода восстановления. Симптомами осложнения, которые должны настораживать, являются:
- болевые проявления;
- зуд;
- возникновение внезапной светобоязни;
- дискомфортные ощущения;
- открытие кровотечения;
- резкая смена показателей внутриглазного давления;
- отечность;
- астигматизм;
- появление воспаления.
Риски пересадки роговицы
Кератопластика, как и все хирургические процедуры, предполагает определенные риски и осложнения для пациента. Некоторые из них:
- Reazo del nuevo tejido.
- Глазные инфекции.
- Kатаракта.
- Астигматизм послеоперационный.
- кровотечение.
- Глаукома.
- Потеря зрения.
- Воспаление роговицы.
Какой врач проводит операцию
Кератопластику проводит хирург. Для операции используется общая или местная анестезия. Лучше всего использовать общее обезболивание, которое поможет обездвижить пациента и предотвратить риски возможных травм роговицы.
Непосредственно перед операцией исследуют роговицу, используя биомикроскопический метод. Просматривая роговицу через щелевую лампу, определяется характер, размер и глубина недуга. Также изучаются слои роговицы. Дополнительно используются специальные методы исследования:
- измеряется толщина роговицы – методом пахиметрии;
- проводится видеокератоскопия;
- берется соскоб роговицы для микробиологического исследования;
- берется материал на биопсию роговицы.
Цена кератопластики
Цена операции по пересадке роговицы может варьироваться в зависимости от вида кератопластики, уровня центра, где осуществляется операция, оборудования и сложности выполнения. Поскольку операция относится к высокотехнологичной медицинской помощи, есть вариант получения квоты для бесплатной имплантации. Такая карта выдается региональным Министерством здравоохранения.
Существует также вариант платной пересадки донорской роговицы. В этом случае придется оплатить операцию, средняя стоимость которой не менее 100 тысяч рублей. Дополнительно следует оплатить донорский орган примерно с такой же стоимостью.
Как проводится операция по пересадке радужки глаза. Сюжет из Чебоксар
Филиал «Микрохирургии глаза» имени Святослава Фёдорова в Чебоксарах за время своего существования не раз подтверждал статус одного из прогрессивных медицинских учреждений не только в России, но и в мире. На счету хирургов-офтальмологов этого центра много уникальных операций, одна из которых – пересадка искусственной радужки глаза.
Надежда Поздеева, профессор:
На самом деле пациенты попадают такие не столь часто, и в год у нас в клинике мы выполняем около 30-40 операций, но это операции очень редкие, они уникальные, выполняются в единичных клиниках не только в России, но и во всём мире.
Есть 2 варианта, когда человек может оказаться без радужки: первый – врождённая патология, второй -последствие серьёзной травмы. Многие читают, что радужка определяет только цвет глаз человека, однако, это очень важная часть глаза.
Надежда Поздеева, профессор:
Это так же, как диафрагм в фотоаппарате: для того чтобы было чёткое изображение, мы должны регулировать размер диафрагма, точно так же радужная оболочка выполняет функцию диафрагмы.
При утрате радужки человеку просто необходимо её восстановление, в первую очередь, для того, чтобы чётко видеть окружающий мир, а также для устранения эстетического дефекта.
Надежда Поздеева, профессор:
Искусственную радужку, которую мы применяем для восстановления функции утерянной радужной оболочки, можно использовать только при посттравматической так называемой аниридии, аниридия – это отсутствие радужной оболочки, мы используем искусственный протез радужной оболочки, который имеет очень маленькую толщину – около 200 микрон. Искусственные радужки могут быть самого разного цвета, совершенно разного рисунка.
Как правило, вследствие травмы человек теряет радужку вместе с хрусталиком, поэтому во время операции проводится комбинированная замена как радужки, так и хрусталика глаза.
Надежда Поздеева, профессор
: Человек, оперирующий искусственную радужку, должен уметь одновременно и глаукому прооперировать, и сетчатку прооперировать, и стекловидное тело, и сделать одновременно пересадку роговицы, то есть это должен быть универсал, который может выйти из самой сложной ситуации.
Искусственные радужки российского производства выполнены из гибкого полимера, они абсолютно инертны и безопасны для глаза и не имеют аналогов в мире. Уже сегодня самые крупные клиники Европы, Канады и Америки начали использовать их при трансплантации.